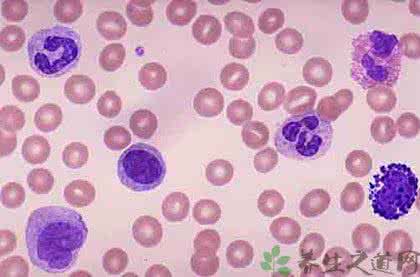
什么原因导致白细胞低 白细胞高的原因 多种原因导致白细胞高

对于白细胞,相信很多人都是知道的,毕竟我们曾经都有学过白细胞的有关知识。那如果当白细胞高的时候,应该怎么办呢?白细胞高又是什么原因引起的呢?今天小编就来为大家一一解答一下。想知道的朋友就来看一下吧。
白细胞高怎么办
在我们生活中,往往会有一些人会出现白细胞高的情况。那白细胞高的时候应该怎么办呢?下面我们不妨一起来看一下。
预防感染,慎重某些引起白细胞增多的药物,如某些抗生素和儿茶酚胺类药物等。
适度运动和体力劳动。放松心情,规律饮食可调节因生理因素引起白细胞增高。
白细胞增多一般是感染的征象,如果有乏力、发热、感染的病史,提示白细胞增多,需要抗感染治疗。建议去医院血常规详细资料让医生看一下,除了感染,白血病也能引起白细胞增多。
白细胞高的原因
以上我们也是知道了白细胞高应该怎么办了,那白细胞高是什么原因引起的呢?想知道话,就一起来看一下吧。
1、病理性白细胞增高
(1)某些细菌性感染所引发的疾病
特别是化脓性球菌引起的局部炎症和全身性感染,如:脓肿、化脓性脑膜炎、肺炎、阑尾炎、中耳炎、扁桃体炎、脓胸、肾盂炎、输卵管炎、胆囊炎及败血症等。
(2)某些病毒性感染所导致的疾病
乙型脑炎,传染性单核细胞增多症,麻疹等。
(3)严重的组织损伤或坏死
如果患者进行大手术或者是被烧伤,亦或者是出现急性出血严重创伤和血管栓塞的话,则是会导致白细胞高的。
(4)过敏反应
如输血反应,药物过敏,急性变态反应性疾病等。
(5)中毒反应
如各种药物中毒,农药中毒,重金属中毒,糖尿病酸中毒,妊娠中毒症等。
爱华网



